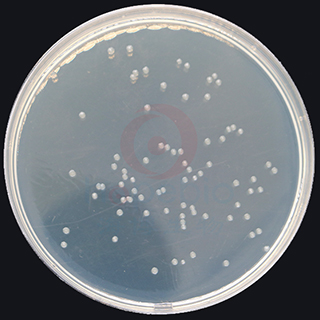
产品细节图片3

万千商家帮你免费找货
0 人在求购买到急需产品
- 详细信息
- 文献和实验
- 技术资料
- 保存条件:
请置于阴凉干燥处保存
- 保质期:
三年
- 英文名:
Aliz-gal Agar
- 库存:
100
- 供应商:
青岛海博生物
- 规格:
100g
风险提示:丁香通仅作为第三方平台,为商家信息发布提供平台空间。用户咨询产品时请注意保护个人信息及财产安全,合理判断,谨慎选购商品,商家和用户对交易行为负责。对于医疗器械类产品,请先查证核实企业经营资质和医疗器械产品注册证情况。
文献和实验一种能把乳糖水解成葡萄糖和半乳糖的酶。 EC3. 2. 1. 23。一般是指能将β -半乳糖苷水解为半乳糖和糖苷的酶。很早以来,就被认为是大肠杆菌诱导酶的典型。分子量 54万,为四聚体。其结构基因为 LacZ,与 LacY(半乳糖苷透性酶)和 LacA(半乳糖苷转乙酰酶)同组成乳糖操纵子,并在特异的乳糖操纵系统中的阻遏物、操纵基因、启动子等的协同下,支配调节β -半乳糖苷酶的合成。当培养基中无诱导物质时,每一细胞中虽然没有几个分子的β -半乳糖苷酶;但一旦被诱导,则每一
邻硝基苯-β-吡喃半乳糖苷 O-nitrophenyl-β-D-galactopyranoside
缩写为 ONPG。是广泛利用于β -半乳糖苷酶活力测定的底物。水解后可游离出邻硝基酚,由于邻硝基酚在碱性条件下呈黄色( 420毫微米光吸收),所以容易进行比色定量。另外利用这种性质,还可用于分离各种代谢调节突变株。
酵母 β -半乳糖苷酶的测定 1) 粗提取物测定 1. 在适当温度下(通常 30 ℃),用适当培养液将 5ml 细胞培养物培养到浓度为 1 × 107 ~ 2 × 107 细胞 /ml 。如果自主复制质粒的杂合基因表达,可使用一种适当培养基对存在质粒的菌株进行筛选。 2. 在冰上冷却细胞,离心收集。注意:以下步骤保持细胞在冰上。 3. 弃上清液,将细胞悬浮于 250 μ
技术资料暂无技术资料 索取技术资料